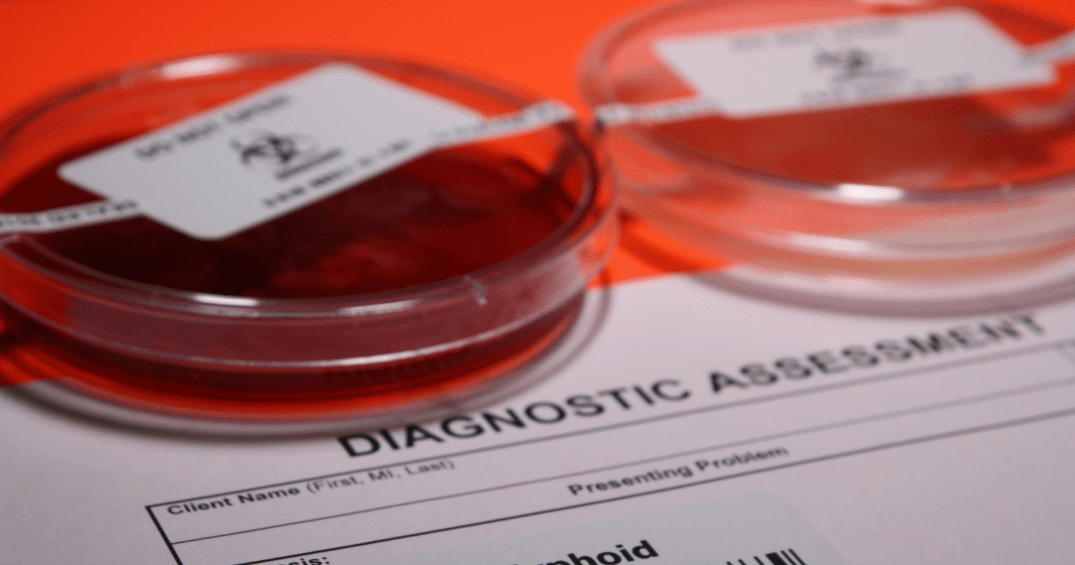

Una infección de las vías urinarias es una infección que se produce en cualquier parte del aparato urinario: los riñones, los uréteres, la vejiga y la uretra. La mayoría de las infecciones ocurren en las vías urinarias inferiores (la vejiga y la uretra). Las mujeres son más propensas a contraer una infección urinaria que los hombres.

Las infecciones urinarias pueden comprender los siguientes síntomas:
- Necesidad imperiosa y constante de orinar
- Ardor al orinar
- Orinar frecuentemente en pequeñas cantidades
- Orina de aspecto turbio
- Orina de color rojo, rosa brillante o amarronado (un signo de sangre en la orina)
- Orina con olor fuerte
- Dolor pélvico
En los adultos mayores, puede que las infecciones urinarias se pasen por alto o se confundan con otras afecciones, en hombres, se acompañan de otras patologías como la hiperplasia prostatica, estenosis de uretra, o cualquier patología que impida un correcto flujo de orina.
El tratamiento de una infección urinaria deberá ser con antibióticos específicos para vía urinaria y también debe buscar resolver la causa por la cual se origino la infección urinaria, en mujeres ( cistitis, trastornos hormonales, cistocele -vejiga caída- ) en hombres ( prostatitis, hiperplasia prostatica – próstata inflamada, agrandada-, estenosis de uretra, etc)
Así que si presentas algún síntoma ó simplemente quieres saber mas información, acércate a un medico especialista certificado en urología y revísate.
Recuerda la prioridad, es tu SALUD
Tu Salud en Manos de Esepcialistas